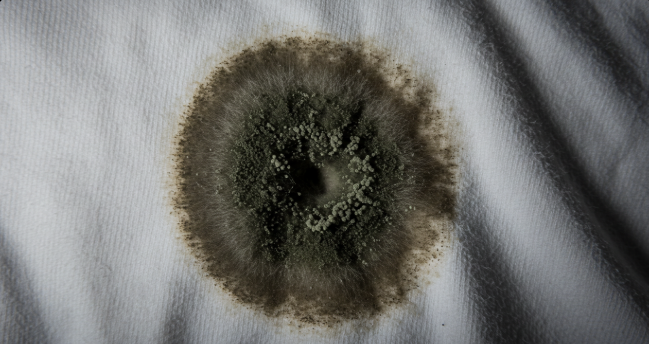

옷에 생긴 곰팡이(진균) 제거하는 방법
옷에 곰팡이나 진균이 생기면 얼룩과 악취가 발생할 뿐만 아니라 피부 알레르기나 호흡기 문제를 유발할 수 있습니다. 특히 습기가 많은 환경에서 보관된 옷은 곰팡이가 쉽게 번식하기 때문에 빠른 조치가 필요합니다.
이번 글에서는 옷에 생긴 곰팡이를 효과적으로 제거하는 방법과 예방하는 팁을 알려드리겠습니다.
1. 옷에 곰팡이가 생기는 원인
곰팡이는 따뜻하고 습한 환경에서 번식합니다. 옷에 곰팡이가 생기는 주요 원인은 다음과 같습니다.
- 높은 습도: 장마철이나 겨울철 실내 습도가 높을 때 옷에 곰팡이가 생기기 쉽습니다.
- 젖은 상태로 보관된 옷: 완전히 마르지 않은 옷을 옷장에 넣으면 곰팡이가 발생할 가능성이 높아집니다.
- 환기 부족: 옷장이 밀폐되어 있거나 공기가 통하지 않으면 곰팡이가 자라기 쉬운 환경이 됩니다.
- 오래된 얼룩: 땀이나 음식물이 묻은 채 방치된 옷은 곰팡이가 번식하기 좋은 조건을 제공합니다.
이러한 원인을 사전에 차단하면 옷에 곰팡이가 생기는 것을 방지할 수 있습니다.



2. 옷에 생긴 곰팡이 제거 방법
옷의 소재에 따라 곰팡이를 제거하는 방법이 다르므로 적절한 세탁법을 선택해야 합니다.
(1) 면, 합성섬유 옷의 곰팡이 제거
식초 또는 베이킹소다 활용
- 따뜻한 물 2L에 식초 1컵 또는 베이킹소다 2큰술을 넣고 섞습니다.
- 곰팡이가 생긴 옷을 담가 30~60분간 불립니다.
- 부드러운 솔로 얼룩을 문지른 후, 일반 세탁기로 세탁합니다.
산소계 표백제 사용 (흰색 옷에만 추천)
물에 산소계 표백제를 희석하여 1~2시간 담갔다가 세탁하면 효과적입니다. 염소계 표백제(락스)는 색상이 있는 옷을 변색시킬 수 있으므로 주의하세요.

(2) 울, 실크 등 민감한 소재의 곰팡이 제거
알코올(소독용 에탄올)과 물을 1:1 비율로 섞어 사용
- 부드러운 천이나 스펀지를 알코올 용액에 적십니다.
- 곰팡이가 있는 부위를 가볍게 닦아줍니다.
- 미지근한 물로 헹군 후 통풍이 잘 되는 곳에서 자연 건조합니다.
(3) 냄새까지 심할 때 추가 세탁 방법
- 과산화수소(3%) 활용: 곰팡이 얼룩이 심할 경우 과산화수소를 얼룩 부분에 바르고 10~15분 후 세탁하면 효과적입니다.
- 베이킹소다 추가 세탁: 일반 세제에 베이킹소다 ½컵을 추가하면 냄새 제거에 도움이 됩니다.
- 햇볕 건조: 세탁 후 햇볕에 완전히 말리면 자외선이 곰팡이균을 제거하는 효과가 있습니다.


3. 옷의 곰팡이 냄새 제거 방법
세탁 후에도 남아 있는 퀴퀴한 곰팡이 냄새는 다음 방법으로 없앨 수 있습니다.
- 햇빛에 말리기: 햇볕의 자외선이 곰팡이균을 살균하고 냄새를 제거하는 데 효과적입니다.
- 식초 헹굼: 마지막 헹굼 단계에서 식초 1컵을 넣으면 곰팡이 냄새를 중화할 수 있습니다.
- 커피 가루 활용: 보관 전 커피 가루를 신문지에 싸서 옷장에 넣어두면 습기를 흡수하고 냄새를 제거할 수 있습니다.
4. 옷 곰팡이 예방하는 방법
(1) 옷장 습기 관리
옷장에 제습제 또는 숯을 배치하면 습기를 흡수하여 곰팡이 생성을 예방할 수 있습니다. 실내 환기를 주기적으로 하여 습기가 차지 않도록 합니다.
(2) 세탁 후 완전 건조 후 보관
젖은 옷을 옷장에 바로 넣지 말고 완전히 건조한 후 보관하세요. 장마철에는 선풍기나 제습기를 이용해 빠르게 건조하는 것이 좋습니다.
(3) 오래 보관하는 옷 관리 방법
계절이 지난 옷은 진공 압축팩에 넣어 보관하면 습기로부터 보호할 수 있습니다. 방충제와 함께 보관하면 곰팡이와 벌레 피해를 방지할 수 있습니다.



5. 결론: 곰팡이 예방과 관리로 옷을 깨끗하게 유지하자!
곰팡이는 습한 환경에서 쉽게 번식하므로, 옷장 환경을 관리하고, 세탁 후 철저히 건조하는 것이 중요합니다.
옷에 곰팡이가 생겼다면 식초, 베이킹소다, 과산화수소, 알코올 등을 활용한 세탁법으로 효과적으로 제거할 수 있으며, 햇볕에 충분히 말려 냄새까지 완벽하게 없애세요.
올바른 관리 습관을 들이면 곰팡이 걱정 없이 옷을 오래도록 깨끗하게 사용할 수 있습니다!
